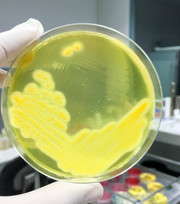

You'll receive the latest updates on new standards, guidelines, and educational resources, as well as expert insights to help enhance your laboratory's performance and compliance.
Press Releases
Catch up on the latest news and updates from CLSI.
View All News Posts
Filters
{{ sortLabels[option] }}
November 5, 2019
CLSI has published NBS08—Newborn Screening for Hemoglobinopathies which describes the newborn screening (NBS) processes for testing dried blood spot specimens to detect hemoglobinopathies and thalassemias not usually evident at birth.
September 12, 2019
CLSI has published AUTO15—Autoverification of Medical Laboratory Results for Specific Disciplines provides general guidance on design and validation of an autoverification system.
August 15, 2019
Presented by CLSI, read the article, “Practical Approach to Evaluating Requests to Test New Antimicrobials,” byCatherine A. Hogan, Stanford University School of Medicine.
August 14, 2019
Read CLSI Publishes Newborn Screening Document and other press releases
August 13, 2019
Emirates National Accreditation System (ENAS) and the Clinical and Laboratory Standards Institute (CLSI) join forces in the pursuit of improving medical laboratory testing in the UAE.
CLSI News
August 8, 2019
Read CLSI publishes new document VET09 and other press releases
June 19, 2019
Read "QMS01: A Quality Management System Model for Laboratory Services" and other press releases from the Clinical and Laboratory Standards Institute.
April 23, 2019
Read CLSI publishes new document GP33 and other press releases
March 25, 2019
CLSI Publishes New Quality Management Document QMS12— Developing and Using Quality Indicators for Laboratory Improvement
February 27, 2019
Presented by CLSI, read the article, “The Cefazolin Inoculum Effect for MSSA,” byWilliam R. Miller and Cesar A. Arias of UTHealth McGovern Medical School.
No Results
No results were returned for that query.